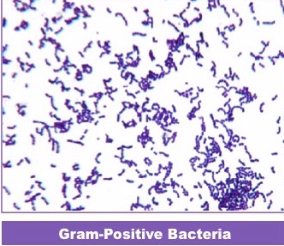
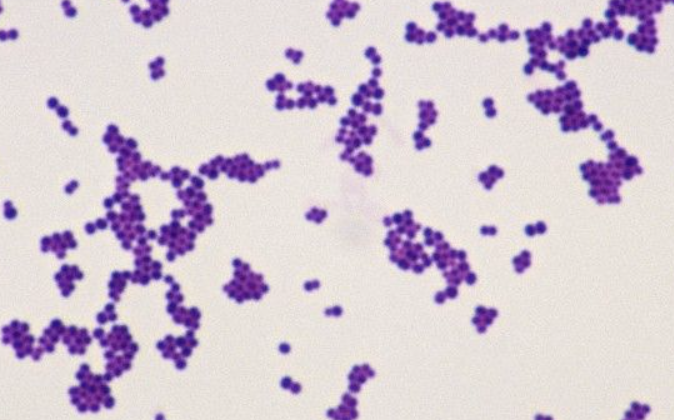

gram staining process acronyms
Fans Can Intimidate Dad Sadly
outline gram staining process
gram positive results
will stain purple due to sufficient peptidoglycan layer
gram negative results
will stain pink- insufficient peptidoglycan layer to retain safranin

Gram positive cocci’s
staplyloccocus
streptococcus
which test is used to differentiate straphyloccocus
coagulase
staphyloccus bacteria with a negative coagulase test
staphylococcus epidermidis
staphyloccus bacteria with a positive coagulase test
Staphylococcus aureus
which test is used to differnetiate streptooccus bacteria
Hemolysis
partial hemolysis
alpha
complete haemolysis
beta
no haemoloysis
Y- gamma
alpha streptococci
partial haemolysis
Beta streptococci
complete haemolysis
gamma streptococci
no haemolysis
streptococcus or staphyloccocus

Gram positive streptococcus
streptococcus or staphylococcus
gram positive staphylococcus
name 4 gram positive bacillus
clostridium
listeria
cornyebacterium
lactobacillus
name the gram negative cocci
nesseria meningitidis- diplococcus

name all gram negative bacillus
Legionella
Yersinia
Escherichia
Vibrio (comma shaped)
Salmonella
Helicobacter (comma shaped)
Shigella
Enterobacter
are gram negative bacteria usually cocci or bacillus
baciilus
are gram posiitve bacteria usually bacillus or rod
mixed